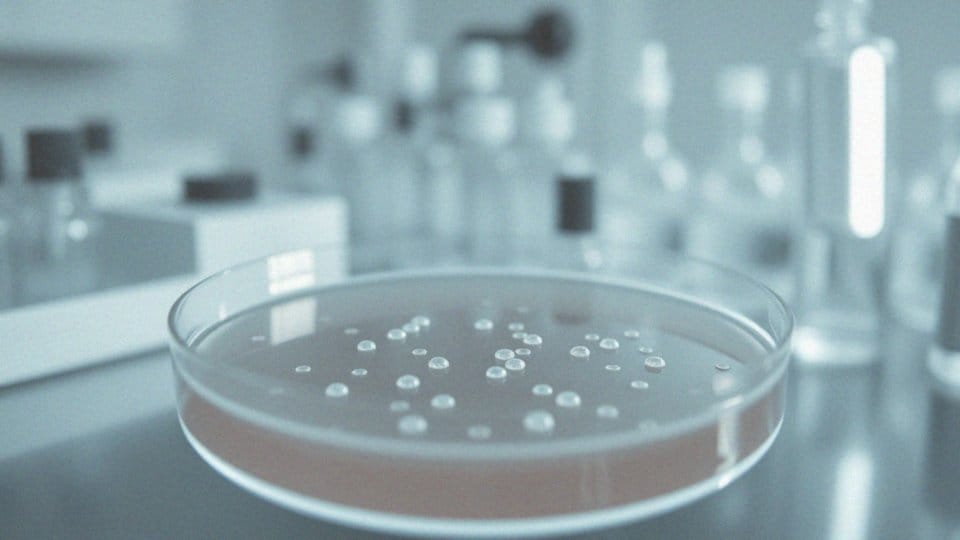

Spis treści
Co to jest _Escherichia coli_?
Escherichia coli, powszechnie znana jako E. coli, to rodzaj bakterii, która naturalnie występuje w jelitach zarówno ludzi, jak i zwierząt. Pełni szereg istotnych funkcji w naszym układzie pokarmowym, pomagając w trawieniu pokarmów oraz chroniąc nas przed szkodliwymi mikroorganizmami. Większość szczepów E. coli jest zupełnie nieszkodliwa, jednak istnieją pewne, jak E. coli O157:H7, które mogą wywołać poważne dolegliwości zdrowotne, takie jak:
- zatrucia pokarmowe,
- infekcje dróg moczowych.
Te bakterie mogą dostać się do organizmu różnymi drogami. Najczęściej dochodzi do infekcji przez spożycie zanieczyszczonej żywności bądź wody, ale możliwe jest również zakażenie poprzez kontakt z osobami noszącymi patogeny. Dlatego zachowanie higieny osobistej ma kluczowe znaczenie. Szczególną uwagę należy zwrócić na czystość w rejonie odbytu, gdzie bakterie mogą łatwo się rozmnażać. Regularne mycie rąk oraz prawidłowe przygotowywanie potraw może znacznie ograniczyć ryzyko zarażenia się E. coli. Problemy zdrowotne wywołane przez tę bakterię są szczególnie groźne dla osób z osłabionym układem odpornościowym, które są bardziej podatne na infekcje. Co więcej, E. coli może również wpłynąć na florę bakteryjną w pochwie, co jest istotnym zagadnieniem zwłaszcza dla kobiet po stosunkach seksualnych. Takie sytuacje mogą prowadzić do intymnych zakażeń oraz zapaleń pęcherza. Zrozumienie znaczenia E. coli dla naszego zdrowia jest kluczowe, aby skutecznie zapobiegać ewentualnym zakażeniom.
Jak _Escherichia coli_ wpływa na zdrowie?
Escherichia coli, powszechnie nazywana E. coli, odgrywa istotną rolę w ludzkim zdrowiu. Jest to naturalny składnik flory jelitowej, który wspiera procesy trawienne oraz produkcję kluczowych witamin. Niestety, niektóre jej szczepy mogą być przyczyną poważnych zakażeń, szczególnie w układzie moczowym. Do typowych objawów takich infekcji należą:
- ból brzucha,
- pieczenie podczas oddawania moczu,
- częstsza potrzeba korzystania z toalety.
Zakażenie E. coli może prowadzić do zapalenia pęcherza moczowego, co z pewnością jest źródłem dyskomfortu i potencjalnie groźnych komplikacji, zwłaszcza u osób z osłabioną odpornością. Z tego względu przestrzeganie zasad higieny osobistej jest niezmiernie istotne. Warto unikać ryzykownych sytuacji podczas intymnych kontaktów, aby ograniczyć rozwój tej bakterii w wrażliwych obszarach. Co więcej, E. coli wpływa również na równowagę flory bakteryjnej, co może sprzyjać pojawianiu się różnych infekcji. Utrzymywanie tej równowagi jest kluczowe dla ogólnego zdrowia oraz odporności na infekcje. Regularne monitorowanie własnego samopoczucia i konsultacje z lekarzem w przypadku niepokojących objawów mogą przyczynić się do szybkiej diagnozy i skutecznego leczenia infekcji wywołanych przez E. coli.
Jakie są sposoby przenoszenia _E. coli_?
Bakterie Escherichia coli przenoszą się głównie drogą fekalno-oralną, co oznacza, że zakażenie najczęściej wynika z zanieczyszczonej żywności lub wody. Ryzyko infekcji wzrasta w przypadku kontaktu z osobami lub zwierzętami, które są nosicielami tych bakterii. Niedostateczna higiena, na przykład niewłaściwe mycie rąk po korzystaniu z toalety, również sprzyja zakażeniom.
Szczególnie niebezpieczny może być seks analny, ponieważ ułatwia przenoszenie bakterii z okolic odbytu do dróg moczowych. Dlatego kluczowym elementem profilaktyki jest dbanie o higienę w tych miejscach. Regularne mycie rąk jest także niezwykle istotne. Co więcej, aktywności takie jak jazda na rowerze mogą prowadzić do kontaktu z zanieczyszczonymi powierzchniami, co zwiększa ryzyko. Warto zatem zachować ostrożność w takich sytuacjach.
Regularne kontrole zdrowia oraz uważność w relacjach intymnych mają ogromne znaczenie w zapobieganiu infekcjom wywoływanym przez E. coli. Zrozumienie, jak te bakterie się przenoszą, jest kluczowe, by ograniczyć ryzyko zakażeń i zadbać o własne zdrowie.
W jaki sposób aktywność seksualna zwiększa ryzyko zakażeń układu moczowego?

Aktywność seksualna, w tym zarówno stosunki analne, jak i waginalne, może zwiększać ryzyko wystąpienia zakażeń układu moczowego. W dużej mierze jest to spowodowane mechanicznym przenoszeniem bakterii, takich jak Escherichia coli, do cewki moczowej. Na przykład, w trakcie zbliżenia, kiedy nie następuje zmiana prezerwatywy po stosunku analnym, bakterie mogą przemieszczać się z okolic odbytu w stronę cewki moczowej, co sprzyja rozwojowi infekcji. Również uszkodzenia, które mogą wystąpić w trakcie współżycia, mogą ułatwiać bakteriom wniknięcie do układu moczowego, co prowadzi do poważnych schorzeń, takich jak zapalenie pęcherza.
Kobiety są szczególnie narażone na te przypadłości, ze względu na bliskość anatomiczną cewki moczowej i odbytu. Statystyki wskazują, że panie częściej niż mężczyźni doświadczają infekcji dróg moczowych, co może być w części związane z ich aktywnością seksualną. Dlatego istotne jest zachowanie ostrożności oraz przestrzeganie zasad higieny przed i po współżyciu, co może znacząco zredukować ryzyko zakażeń. Podnoszenie świadomości na temat zagrożeń związanych z E. coli oraz dbałość o zdrowie intymne odgrywają kluczową rolę w prewencji podczas aktywności seksualnej.
Jak _E. coli_ może prowadzić do zapalenia pęcherza moczowego?
Bakterie Escherichia coli, a zwłaszcza niektóre ich szczepy, stanowią najczęstszy powód zapalenia pęcherza moczowego. Zazwyczaj dostają się do pęcherza z okolic odbytu, co często jest efektem niewłaściwej higieny lub wynikiem aktywności seksualnej. Podczas stosunków płciowych bakterie te mogą z łatwością wniknąć do układu moczowego, szczególnie u kobiet ze względu na krótszą cewkę moczową. Gdy E. coli przedostaje się do pęcherza, przyczepia się do jego ścianek, co prowadzi do stanu zapalnego.
Typowe objawy zapalenia pęcherza to:
- ból w dolnej części brzucha,
- uczucie pieczenia podczas oddawania moczu,
- częste wizyty w toalecie.
Nieleczona infekcja może prowadzić do poważnych komplikacji zdrowotnych. Dlatego osoby aktywne seksualnie powinny być świadome ryzyka związanego z E. coli. Kluczowe jest przestrzeganie zasad higieny intymnej oraz dbałość o czystość zarówno przed, jak i po każdym stosunku. Unikanie sytuacji sprzyjających przenoszeniu tych bakterii jest niezbędnym krokiem w kierunku zapobiegania zapaleniu pęcherza moczowego.
Jakie są objawy zakażenia _E. coli_?
Zakażenie E. coli może manifestować się na wiele sposobów, w zależności od lokalizacji infekcji. Objawy zakażeń układu moczowego obejmują:
- częste i bolesne oddawanie moczu,
- pieczenie,
- silne parcie na pęcherz,
- dyskomfort w dolnym brzuchu,
- zmiany w kolorze i zapachu moczu.
Z drugiej strony, infekcje przewodu pokarmowego wywołane przez E. coli zazwyczaj prowadzą do:
- biegunkę, która w niektórych przypadkach może być krwawa,
- ból brzucha,
- nudności,
- wymioty,
- gorączkę oraz ryzyko odwodnienia organizmu.
Warto zaznaczyć, że różne szczepy E. coli mogą powodować różnorodne objawy kliniczne. Dlatego tak istotne jest monitorowanie niepokojących symptomów i niezwłoczne konsultowanie się z lekarzem. Zrozumienie specyfiki tych objawów może znacząco przyspieszyć proces diagnozy, a tym samym skutecznego leczenia infekcji. Szczególnie w kontekście zdrowia intymnego, objawy zakażeń E. coli mogą prowadzić do poważniejszych problemów, dlatego ich zbagatelizowanie nie jest wskazane.
Jak diagnozować zakażenia wywołane przez _E. coli_?
Diagnostyka zakażeń spowodowanych przez E. coli opiera się przede wszystkim na przeprowadzaniu specjalistycznych badań w laboratoriach. Te analizy pozwalają na dokładne zidentyfikowanie bakterii oraz zbadanie ich wrażliwości na różne antybiotyki.
W przypadku podejrzenia infekcji układu moczowego niezwykle istotne jest skontrolowanie próbki moczu. Kluczowym elementem jest posiew, który nie tylko wykrywa obecność E. coli, ale również ocenia skuteczność dostępnych leków.
W odniesieniu do zakażeń przewodu pokarmowego, analizowane są próbki kału, co pozwala na identyfikację drobnoustrojów oraz ocenę ich toksyczności. Badanie kału staje się szczególnie istotne u pacjentów doświadczających objawów biegunkowych czy skarżących się na ból brzucha.
W sytuacjach dotyczących infekcji intymnych, zwłaszcza u kobiet, często wykonuje się wymaz z pochwy. To badanie pozwala na rozpoznanie bakterii oraz analizę flory bakteryjnej, co jest kluczowe, gdyż jej zaburzenia mogą prowadzić do stanów zapalnych.
Szybka i precyzyjna diagnoza jest niezbędna, aby skutecznie leczyć infekcje wywołane przez E. coli. Pomaga to w uniknięciu poważnych problemów zdrowotnych, które mogą się pojawić, jeśli choroba pozostanie nieleczona.
Jakie metody leczenia stosuje się przeciwko _E. coli_?
Leczenie zakażeń wywołanych przez Escherichia coli różni się w zależności od rodzaju infekcji oraz jej lokalizacji. Na przykład, w przypadku infekcji dróg moczowych zadanie to polega na wykorzystaniu różnych antybiotyków. Do skutecznych opcji należą:
- furagina,
- trimetoprim/sulfametoksazol,
- fluorochinolony.
Te leki skutecznie zwalczają wiele szczepów E. coli. Ich efektywność jest ściśle związana z wrażliwością bakterii na określone leki. W kontekście zakażeń pokarmowych, które często objawiają się biegunką oraz bólami brzucha, leczenie zazwyczaj ma charakter objawowy. Kluczowe jest, aby zapewnić odpowiednie nawodnienie organizmu oraz uzupełniać elektrolity. W cięższych przypadkach, gdy objawy są intensywne lub pojawia się ryzyko odwodnienia, lekarze mogą zalecić stosowanie antybiotyków dożylnych, jednak takie decyzje wymagają ostrożności.
Osoby, które mają osłabiony układ odpornościowy lub borykają się z nawracającymi zakażeniami, powinny zasięgnąć porady lekarskiej. Specjalista pomoże w opracowaniu odpowiedniej strategii leczenia i zapobiegania. Dodatkowo, wprowadzenie higienicznych nawyków, takich jak regularne mycie rąk, odgrywa istotną rolę w prewencji zakażeń E. coli oraz zmniejszeniu ryzyka ich nawrotów.
Jak uniknąć zakażenia _E. coli_ podczas współżycia?
Aby zmniejszyć ryzyko zakażenia E. coli podczas intymnych aktywności, kluczowe jest przestrzeganie zasad higieny osobistej. Mycie rąk zarówno przed, jak i po stosunku znacząco ogranicza możliwość przenoszenia niepożądanych bakterii. Ta zasada jest wyjątkowo istotna w przypadku aktywności analnej, gdzie bakterie mogą łatwo przejść z okolic odbytu do cewki moczowej.
Warto pomyśleć o:
- używaniu prezerwatyw podczas seksu analnego,
- wymianie prezerwatyw przed seksem waginalnym,
- oddaniu moczu po współżyciu, co pozwala wypłukać potencjalne patogeny z cewki moczowej.
Warto unikać bliskiego kontaktu z osobami chorymi oraz dbać o higienę intymnych stref. Zastosowanie tych prostych zasad i systematyczna troska o higienę intymną mocno ograniczają ryzyko zakażeń wywołanych przez E. coli oraz inne bakterie. Odpowiednia dbałość o zdrowie intymne jest niezwykle ważna, szczególnie dla kobiet. Dodatkowo, regularne zwracanie uwagi na samopoczucie oraz szybka reakcja na niepokojące objawy są kluczowe dla zachowania dobrego stanu zdrowia.
Jakie są konsekwencje zakażeń intymnych wywołanych przez _E. coli_?
Zakażenia intymne wywołane przez Escherichia coli mogą prowadzić do poważnych problemów zdrowotnych, dotyczących zarówno kobiet, jak i mężczyzn. Dla pań te infekcje często skutkują zapaleniem pochwy, objawiającym się:
- nieprzyjemnymi upławami,
- swędzeniem,
- pieczeniem.
Co więcej, w przypadku, gdy bakterie przenikną do układu moczowego, mogą wywołać zapalenie pęcherza moczowego, co skutkuje intensywnym dyskomfortem i bólem. Jeśli zakażenia nie zostaną odpowiednio leczone, mogą prowadzić do przewlekłych stanów zapalnych, a także zwiększać ryzyko powikłań w ciąży, jak na przykład:
- przedwczesny poród.
Mężczyźni również nie są zwolnieni z tego problemu, ponieważ E. coli często wywołuje zapalenie cewki moczowej oraz prostaty. Objawy są podobne i obejmują ból oraz trudności z oddawaniem moczu. Diagnoza i leczenie zakażeń mogą być skomplikowane, zwłaszcza w przypadku przewlekłych przypadków, co tylko zwiększa ilość problemów zdrowotnych. Pojawienie się zapalenia prostaty może nawet skutkować ciężkimi zaburzeniami funkcji seksualnych.
W kontekście intymnym warto zwrócić uwagę na możliwość zakażenia poprzez kontakt z osobą, która jest już zarażona, a także na znaczenie utrzymania odpowiedniej higieny podczas aktywności seksualnej. Dbałość o zasady higieny osobistej przed i po stosunkach może znacząco zmniejszyć ryzyko zakażeń. W przypadku pojawienia się jakichkolwiek objawów zakażenia, natychmiastowa diagnoza jest kluczowa, aby uniknąć dalszych powikłań. Rozumienie skutków zakażeń wywołanych przez E. coli jest niezwykle istotne dla zachowania zdrowia i ogólnego samopoczucia.
W jaki sposób _E. coli_ wpływa na florę bakteryjną pochwy?

Obecność bakterii Escherichia coli w pochwie, szczególnie gdy ich liczba się zwiększa, ma duży wpływ na naturalną florę bakteryjną. Zazwyczaj dominują tam bakterie Lactobacillus, które odgrywają istotną rolę w utrzymaniu właściwego pH. Działają one jako naturalna bariera, hamując rozwój groźnych patogenów. Jednak nadmiar E. coli może zakłócać tę delikatną równowagę, co w konsekwencji prowadzi do różnych problemów zdrowotnych, na przykład bakteryjnej waginozy.
W takiej sytuacji spada liczba Lactobacillus, a liczebność bakterii beztlenowych rośnie. To zjawisko powoduje podniesienie pH, co z kolei może wiązać się z nieprzyjemnymi objawami, takimi jak:
- swędzenie,
- pieczenie,
- nietypowe upławy.
Co więcej, zmiany w składzie flory bakteryjnej mogą zwiększać podatność na infekcje intymne oraz choroby przenoszone drogą płciową. Równocześnie, korzystna równowaga bakteryjna jest kluczowa dla ochrony przed szkodliwymi czynnikami. Zaburzenia wywołane przez E. coli mogą prowadzić do poważnych schorzeń. Dlatego tak ważne jest dbanie o higienę intymną przed oraz po stosunkach, aby zapobiegać infekcjom. Ważne jest również regularne monitorowanie zdrowia intymnego oraz konsultacje z lekarzem w przypadku wystąpienia niepokojących objawów, co może pomóc w utrzymaniu dobrej kondycji zdrowotnej.
Dlaczego zaburzenia równowagi flory bakteryjnej sprzyjają _E. coli_?
Zaburzenia równowagi flory bakteryjnej, które mogą wynikać na przykład z przyjmowania antybiotyków czy stosowania irygacji pochwy, mogą prowadzić do niepożądanej proliferacji bakterii E. coli. W zdrowym środowisku pochwy przeważają bakterie z rodzaju Lactobacillus, które odgrywają kluczową rolę w utrzymaniu prawidłowego pH, co z kolei chroni przed patogenami.
Kiedy ich liczba spada, E. coli zyskuje lepsze warunki do rozwoju. Utrata zdrowej flory bakteryjnej prowadzi do podwyższenia pH, co sprzyja kolonizacji przez E. coli oraz inne mikroorganizmy. Takie niekorzystne zmiany mogą skutkować stanami zapalnymi i zwiększają ryzyko infekcji intymnych.
Dlatego dbanie o zdrowie flory bakteryjnej jest niezwykle istotne – pozwala to na skuteczną prewencję zakażeń. Regularne wizyty u specjalisty oraz dbałość o higienę intymną mogą pomóc w minimalizowaniu tych zagrożeń.





